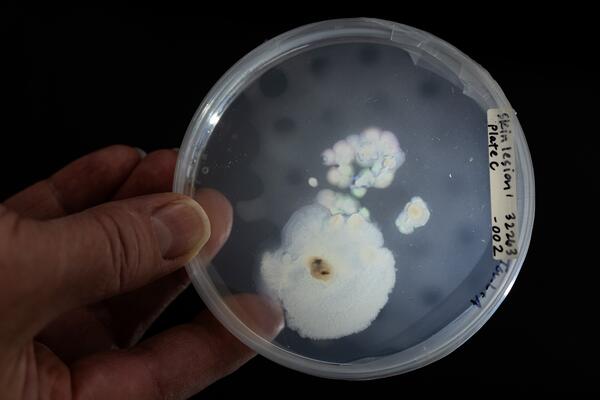
A scientist in a lab holding a salamander skin sample under a light for investigation.

A USGS scientist examines microorganisms from salamander skin to investigate for potential pathogens.
Daniel A Grear
Dan Grear is a Wildlife Disease Ecologist at the National Wildlife Health Center.
I am interested in mechanisms that cause heterogeneities in pathogen transmission in wild animal disease systems and at the interface of wildlife, domestic animal, and human health. I lead investigations into wildlife mortality events and research that incorporates field studies with theoretical modeling of disease systems to identify key mechanisms that drive transmission dynamic.
Professional Experience
2015 - Present Wildlife Disease Ecologist, U.S. Geological Survey, National Wildlife Health Center, Madison, WI
2013 - 2015 Ecologist, U.S. Department of Agriculture, Veterinary Services, Center for Epidemiology and Animal Health, Fort Collins, CO
2011 - 2014 Post-Doctoral Researcher, Colorado State University
Education and Certifications
2011 Ph.D. Ecology, Pennsylvania State University
2006 M.S. Wildlife Ecology, University of Wisconsin
2002 B.S. Wildlife Ecology, University of Wisconsin
Affiliations and Memberships*
Member of the Ecological Society of America
Member of the Wildlife Society
Bsal Task Force Working Group Member
Science and Products
Responding to New World Screwworm in the U.S.
Batrachochytrium salamandrivorans (Bsal)
Batrachochytrium salamandrivorans (Bsal) Surveillance
Forecasting Mosquito Phenology in a Shifting Climate: Synthesizing Continental-scale Monitoring Data
Avian Influenza
Hosts, pathogens, and hot ponds: Thermal variability and heat contribute jointly to spatial patterns of chytrid infection in amphibians in southern Wisconsin, data release Hosts, pathogens, and hot ponds: Thermal variability and heat contribute jointly to spatial patterns of chytrid infection in amphibians in southern Wisconsin, data release
SARS-CoV-2 and Mpox virus spillback component data (North America, 2022) to create risk assessment of spillback at human-wildlife interface SARS-CoV-2 and Mpox virus spillback component data (North America, 2022) to create risk assessment of spillback at human-wildlife interface
Data Release: Coordinated efforts toward understanding a mortality event in wild passerines in the eastern United States: Responses, lessons learned and future recommendations Data Release: Coordinated efforts toward understanding a mortality event in wild passerines in the eastern United States: Responses, lessons learned and future recommendations
Indiana Amphibian Pathogen Surveillance data release Indiana Amphibian Pathogen Surveillance data release
Avian disease screening of translocated sage grouse captured in Montana, USA Avian disease screening of translocated sage grouse captured in Montana, USA
Data Release for Replicate amphibian swab and standard dilution of artificial DNA data to assess qPCR and sampling detection error for Batrachochytrium dendrobatidis. Data Release for Replicate amphibian swab and standard dilution of artificial DNA data to assess qPCR and sampling detection error for Batrachochytrium dendrobatidis.
Avian morbidity and mortality data reported to the Wildlife Health Information Sharing Partnership - event reporting system (WHISPers) in the continental United States for events beginning on or between January 1, 2023 and December 31, 2023 Avian morbidity and mortality data reported to the Wildlife Health Information Sharing Partnership - event reporting system (WHISPers) in the continental United States for events beginning on or between January 1, 2023 and December 31, 2023
Serologic Survey of Selected Arthropod Borne Pathogens in Free-ranging Snowshoe Hares (Lepus americanus) Captured in Northern Michigan, USA Serologic Survey of Selected Arthropod Borne Pathogens in Free-ranging Snowshoe Hares (Lepus americanus) Captured in Northern Michigan, USA
Mercury concentrations in amphibian tissues across the United States, 2016-2021 Mercury concentrations in amphibian tissues across the United States, 2016-2021
Paranannizziopsis spp. associated with skin lesions in wild snakes in North America and development of a real-time PCR assay for rapid detection of the fungus in clinical samples Paranannizziopsis spp. associated with skin lesions in wild snakes in North America and development of a real-time PCR assay for rapid detection of the fungus in clinical samples
Student Network for Amphibian Pathogen Surveillance Data (ver. 2.0, April 2024) Student Network for Amphibian Pathogen Surveillance Data (ver. 2.0, April 2024)
Population genetic analysis of the snake-infecting fungus, Ophidiomyces ophidiicola, in the eastern United States Population genetic analysis of the snake-infecting fungus, Ophidiomyces ophidiicola, in the eastern United States
A USGS scientist examines microorganisms from salamander skin to investigate for potential pathogens.
A USGS scientist reaches for a microbiological plate with cultures from salamander skin to investigate for potential pathogens.
A USGS scientist reaches for a microbiological plate with cultures from salamander skin to investigate for potential pathogens.
A USGS scientist prepares to analyze a skin swab from a salamander to investigate for potential pathogens.
A USGS scientist prepares to analyze a skin swab from a salamander to investigate for potential pathogens.
A USGS scientist examines a skin sample from a salamander as part of a study to investigate for potential pathogens.
A USGS scientist examines a skin sample from a salamander as part of a study to investigate for potential pathogens.
A USGS scientist examines salamanders as part of a study to investigate for potential pathogens.
A USGS scientist examines salamanders as part of a study to investigate for potential pathogens.

Eastern newt (Notophthalmus viridescens) in Wisconsin
Eastern newt (Notophthalmus viridescens) in WisconsinEastern newt (Notophthalmus viridescens) in Wisconsin.
Eastern newt (Notophthalmus viridescens) in Wisconsin
Eastern newt (Notophthalmus viridescens) in WisconsinEastern newt (Notophthalmus viridescens) in Wisconsin.
Annotated bibliography of scientific research on new world screwworm (Cochliomyia hominivorax) myiasis in wildlife Annotated bibliography of scientific research on new world screwworm (Cochliomyia hominivorax) myiasis in wildlife
Conducting feasibility assessments of potential conservation reintroductions: A case study with the imperiled foothill yellow-legged frog, Rana boylii Conducting feasibility assessments of potential conservation reintroductions: A case study with the imperiled foothill yellow-legged frog, Rana boylii
Hosts, pathogens and hot ponds: Thermal mean and variability contribute to spatial patterns of chytrid infection Hosts, pathogens and hot ponds: Thermal mean and variability contribute to spatial patterns of chytrid infection
Rapid risk assessment framework to estimate potential for spillback at human-wildlife interfaces Rapid risk assessment framework to estimate potential for spillback at human-wildlife interfaces
Independent and interactive effects of disease and methylmercury on demographic rates across multiple amphibian populations Independent and interactive effects of disease and methylmercury on demographic rates across multiple amphibian populations
Pan-amphibia distribution of the fungal parasite Batrachochytrium dendrobatidis varies with species and temperature Pan-amphibia distribution of the fungal parasite Batrachochytrium dendrobatidis varies with species and temperature
An enigmatic wild passerine mortality event in the eastern United States An enigmatic wild passerine mortality event in the eastern United States
Partly cloudy with a chance of mosquitoes: Developing a flexible approach to forecasting mosquito populations Partly cloudy with a chance of mosquitoes: Developing a flexible approach to forecasting mosquito populations
Morbidity in California giant salamander (Dicamptodon ensatus Eschscholtz, 1833) caused by Euryhelmis sp. Poche, 1926 (Trematoda: Heterophyiidae) Morbidity in California giant salamander (Dicamptodon ensatus Eschscholtz, 1833) caused by Euryhelmis sp. Poche, 1926 (Trematoda: Heterophyiidae)
Serologic survey of selected arthropod-borne pathogens in free-ranging snowshoe hares (Lepus americanus) captured in Northern Michigan, USA Serologic survey of selected arthropod-borne pathogens in free-ranging snowshoe hares (Lepus americanus) captured in Northern Michigan, USA
Chytrid infections exhibit historical spread and contemporary seasonality in a declining stream-breeding frog Chytrid infections exhibit historical spread and contemporary seasonality in a declining stream-breeding frog
Paranannizziopsis spp. infections in wild snakes and a qPCR assay for detection of the fungus Paranannizziopsis spp. infections in wild snakes and a qPCR assay for detection of the fungus
Non-USGS Publications**
**Disclaimer: The views expressed in Non-USGS publications are those of the author and do not represent the views of the USGS, Department of the Interior, or the U.S. Government.
Pan-Amphibia Bd distribution: software release Pan-Amphibia Bd distribution: software release
Science and Products
Responding to New World Screwworm in the U.S.
Batrachochytrium salamandrivorans (Bsal)
Batrachochytrium salamandrivorans (Bsal) Surveillance
Forecasting Mosquito Phenology in a Shifting Climate: Synthesizing Continental-scale Monitoring Data
Avian Influenza
Hosts, pathogens, and hot ponds: Thermal variability and heat contribute jointly to spatial patterns of chytrid infection in amphibians in southern Wisconsin, data release Hosts, pathogens, and hot ponds: Thermal variability and heat contribute jointly to spatial patterns of chytrid infection in amphibians in southern Wisconsin, data release
SARS-CoV-2 and Mpox virus spillback component data (North America, 2022) to create risk assessment of spillback at human-wildlife interface SARS-CoV-2 and Mpox virus spillback component data (North America, 2022) to create risk assessment of spillback at human-wildlife interface
Data Release: Coordinated efforts toward understanding a mortality event in wild passerines in the eastern United States: Responses, lessons learned and future recommendations Data Release: Coordinated efforts toward understanding a mortality event in wild passerines in the eastern United States: Responses, lessons learned and future recommendations
Indiana Amphibian Pathogen Surveillance data release Indiana Amphibian Pathogen Surveillance data release
Avian disease screening of translocated sage grouse captured in Montana, USA Avian disease screening of translocated sage grouse captured in Montana, USA
Data Release for Replicate amphibian swab and standard dilution of artificial DNA data to assess qPCR and sampling detection error for Batrachochytrium dendrobatidis. Data Release for Replicate amphibian swab and standard dilution of artificial DNA data to assess qPCR and sampling detection error for Batrachochytrium dendrobatidis.
Avian morbidity and mortality data reported to the Wildlife Health Information Sharing Partnership - event reporting system (WHISPers) in the continental United States for events beginning on or between January 1, 2023 and December 31, 2023 Avian morbidity and mortality data reported to the Wildlife Health Information Sharing Partnership - event reporting system (WHISPers) in the continental United States for events beginning on or between January 1, 2023 and December 31, 2023
Serologic Survey of Selected Arthropod Borne Pathogens in Free-ranging Snowshoe Hares (Lepus americanus) Captured in Northern Michigan, USA Serologic Survey of Selected Arthropod Borne Pathogens in Free-ranging Snowshoe Hares (Lepus americanus) Captured in Northern Michigan, USA
Mercury concentrations in amphibian tissues across the United States, 2016-2021 Mercury concentrations in amphibian tissues across the United States, 2016-2021
Paranannizziopsis spp. associated with skin lesions in wild snakes in North America and development of a real-time PCR assay for rapid detection of the fungus in clinical samples Paranannizziopsis spp. associated with skin lesions in wild snakes in North America and development of a real-time PCR assay for rapid detection of the fungus in clinical samples
Student Network for Amphibian Pathogen Surveillance Data (ver. 2.0, April 2024) Student Network for Amphibian Pathogen Surveillance Data (ver. 2.0, April 2024)
Population genetic analysis of the snake-infecting fungus, Ophidiomyces ophidiicola, in the eastern United States Population genetic analysis of the snake-infecting fungus, Ophidiomyces ophidiicola, in the eastern United States
A USGS scientist examines microorganisms from salamander skin to investigate for potential pathogens.
A USGS scientist examines microorganisms from salamander skin to investigate for potential pathogens.
A USGS scientist reaches for a microbiological plate with cultures from salamander skin to investigate for potential pathogens.
A USGS scientist reaches for a microbiological plate with cultures from salamander skin to investigate for potential pathogens.
A USGS scientist prepares to analyze a skin swab from a salamander to investigate for potential pathogens.
A USGS scientist prepares to analyze a skin swab from a salamander to investigate for potential pathogens.
A USGS scientist examines a skin sample from a salamander as part of a study to investigate for potential pathogens.
A USGS scientist examines a skin sample from a salamander as part of a study to investigate for potential pathogens.
A USGS scientist examines salamanders as part of a study to investigate for potential pathogens.
A USGS scientist examines salamanders as part of a study to investigate for potential pathogens.

Eastern newt (Notophthalmus viridescens) in Wisconsin
Eastern newt (Notophthalmus viridescens) in WisconsinEastern newt (Notophthalmus viridescens) in Wisconsin.
Eastern newt (Notophthalmus viridescens) in Wisconsin
Eastern newt (Notophthalmus viridescens) in WisconsinEastern newt (Notophthalmus viridescens) in Wisconsin.
Annotated bibliography of scientific research on new world screwworm (Cochliomyia hominivorax) myiasis in wildlife Annotated bibliography of scientific research on new world screwworm (Cochliomyia hominivorax) myiasis in wildlife
Conducting feasibility assessments of potential conservation reintroductions: A case study with the imperiled foothill yellow-legged frog, Rana boylii Conducting feasibility assessments of potential conservation reintroductions: A case study with the imperiled foothill yellow-legged frog, Rana boylii
Hosts, pathogens and hot ponds: Thermal mean and variability contribute to spatial patterns of chytrid infection Hosts, pathogens and hot ponds: Thermal mean and variability contribute to spatial patterns of chytrid infection
Rapid risk assessment framework to estimate potential for spillback at human-wildlife interfaces Rapid risk assessment framework to estimate potential for spillback at human-wildlife interfaces
Independent and interactive effects of disease and methylmercury on demographic rates across multiple amphibian populations Independent and interactive effects of disease and methylmercury on demographic rates across multiple amphibian populations
Pan-amphibia distribution of the fungal parasite Batrachochytrium dendrobatidis varies with species and temperature Pan-amphibia distribution of the fungal parasite Batrachochytrium dendrobatidis varies with species and temperature
An enigmatic wild passerine mortality event in the eastern United States An enigmatic wild passerine mortality event in the eastern United States
Partly cloudy with a chance of mosquitoes: Developing a flexible approach to forecasting mosquito populations Partly cloudy with a chance of mosquitoes: Developing a flexible approach to forecasting mosquito populations
Morbidity in California giant salamander (Dicamptodon ensatus Eschscholtz, 1833) caused by Euryhelmis sp. Poche, 1926 (Trematoda: Heterophyiidae) Morbidity in California giant salamander (Dicamptodon ensatus Eschscholtz, 1833) caused by Euryhelmis sp. Poche, 1926 (Trematoda: Heterophyiidae)
Serologic survey of selected arthropod-borne pathogens in free-ranging snowshoe hares (Lepus americanus) captured in Northern Michigan, USA Serologic survey of selected arthropod-borne pathogens in free-ranging snowshoe hares (Lepus americanus) captured in Northern Michigan, USA
Chytrid infections exhibit historical spread and contemporary seasonality in a declining stream-breeding frog Chytrid infections exhibit historical spread and contemporary seasonality in a declining stream-breeding frog
Paranannizziopsis spp. infections in wild snakes and a qPCR assay for detection of the fungus Paranannizziopsis spp. infections in wild snakes and a qPCR assay for detection of the fungus
Non-USGS Publications**
**Disclaimer: The views expressed in Non-USGS publications are those of the author and do not represent the views of the USGS, Department of the Interior, or the U.S. Government.
Pan-Amphibia Bd distribution: software release Pan-Amphibia Bd distribution: software release
*Disclaimer: Listing outside positions with professional scientific organizations on this Staff Profile are for informational purposes only and do not constitute an endorsement of those professional scientific organizations or their activities by the USGS, Department of the Interior, or U.S. Government